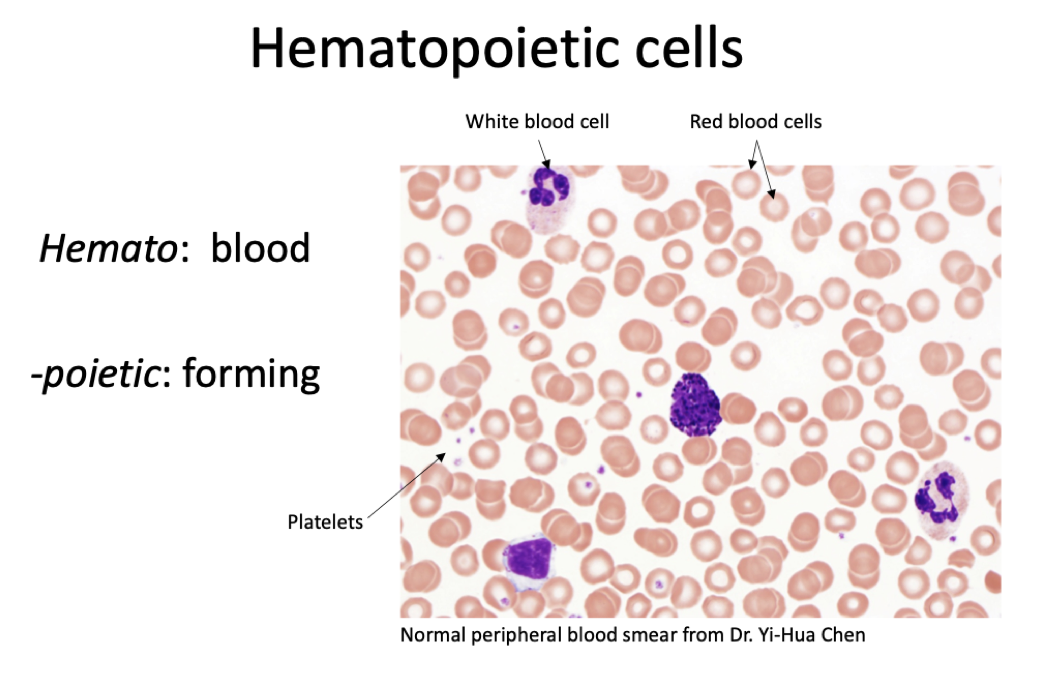
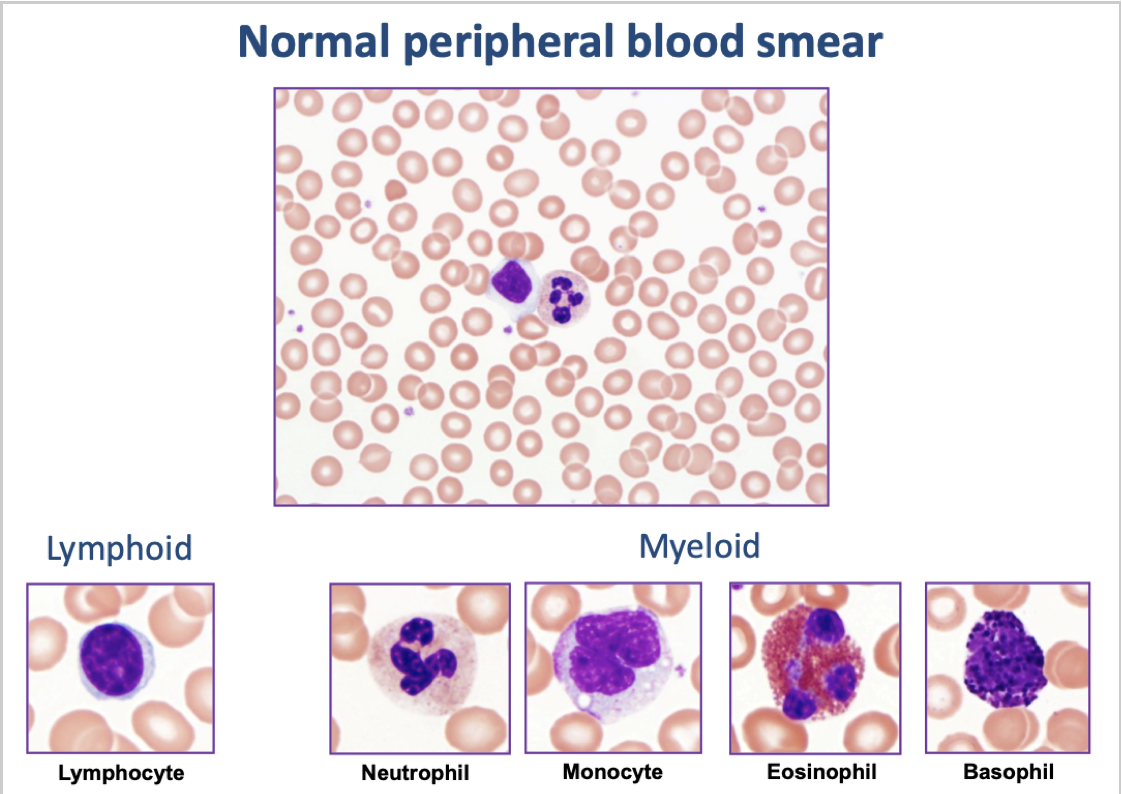

Describe the types of hematopoietic cells
Types of hematopoietic cells
Hematologic malignancies are classified by ____, ____, ____, and ____
Hematologic malignancies are classified by cell of origin, cell maturation, presence of genetic abnormalities, and clinical findings
Describe hematopoietic cell differentiation
Hematopoietic cell differentiation

Myeloid WBCs include ___, ___, ___, and ___
Myeloid WBCs include neutrophils, eosinophils, basophils and mast cells, and antigen-presenting cells (macrophages and dendritic cells)
Lymphoid WBCs are ____, ____, and ____
Lymphoid WBCs are B cells, T cells, and NK cells
Describe normal peripheral blood smear
Normal peripheral blood smear
Describe tissues of the hematopoietic and immune system
Tissues of the hematopoietic and immune system
Primary lymphoid tissues are where ___
Primary lymphoid tissues are where cells originate and develop
Secondary lymphoid tissues are where ___
Secondary lymphoid tissues are where immune response is activated
Describe the myeloid lineage
Myeloid lineage

Neutrophils are part of the ___ immune system and function to ___
Neutrophils are part of the innate immune system and function to ingest and kill pathogens

Myeloid classification includes ____ and ____
Myeloid classification includes RBC derived (erythroid) neoplasms and megakaryocytic neoplasms
Lymphocytes are involved in ___ immunity
Lymphocytes are involved in adaptive immunity
Describe the lymphoid lineage
Lymphoid lineage

Describe B cells
B cells

B cells originate and mature in ___
B cells originate and mature in bone marrow

Describe T cells
T cells

Describe NK cells
NK cells

Describe histiocytic dendritic cell lineage
Histiocytic dendritic cell lineage
Lymphoma is ___
Lymphoma is neoplasms derived from lymphoid cells and typically applied to tissue-based (lymph, spleen, etc) neoplasms
Leukemia is ___
Leukemia is neoplasms originating in the blood and bone marrow, including both myeloid and lymphoid origin
Myeloid sarcoma is ___
Myeloid sarcoma is myeloid neoplasms involving the tissue
Describe ambiguity with leukemia / lymphoma terminology
Ambiguity with leukemia / lymphoma terminology
WHO classification of hematologic malignancy relies on a combination of ___, ___, ___, and ___ features
WHO classification of hematologic malignancy relies on a combination of morphologic, phenotypic, molecular / genetic, and clinical features